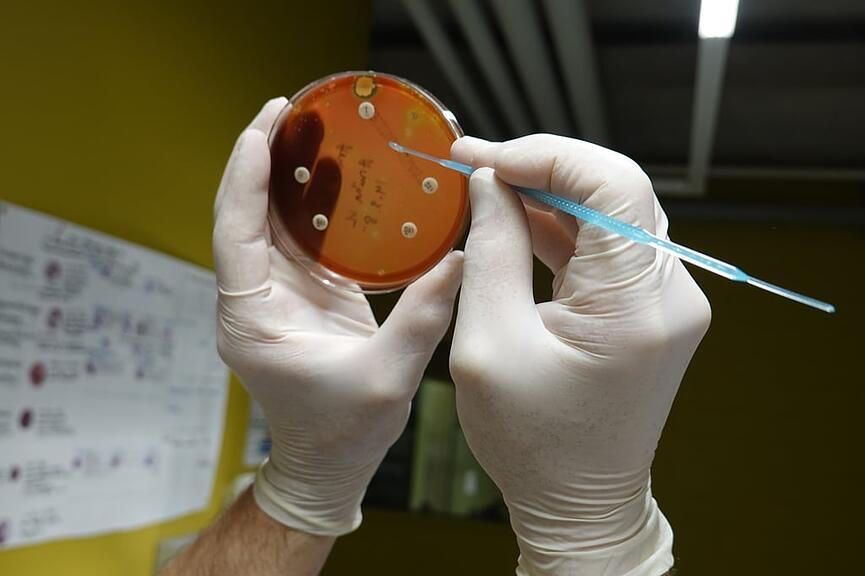

Ein schneereiches Wochenende ist vorüber. Der Himmel klart wieder auf. Kurz nach sieben Uhr brennt Licht in der grosszügig eingerichteten und modernen Gross- und Nutztierpraxis an der Giessenstrasse in Altdorf. Vier Tierärztinnen und zwei Tierärzte leisten im 14-köpfigen Praxisteam rund um die Uhr einen wichtigen Beitrag für die Versorgung der landwirtschaftlichen Nutztiere im Kanton Uri.
Das Telefon läuft heiss an diesem Montagmorgen. «Man weiss nie, was der Tag mit sich bringt», sagt Marc Butty (40), der erfahrene Grosstierarzt. Das Labor, die umfangreiche Apotheke und die beiden Operationsräume stehen ihm zur Verfügung. Das Veterinärauto mit der mobilen Ausrüstung und über 60 Medikamenten steht startklar vor der Garage. Schneeketten sind prophylaktisch an Bord.
Fremdes «Ürner Tytsch»
In der Nähe von Romont ist Marc Butty in einer Tierarztfamilie mit drei Geschwistern aufgewachsen. Nach einem Sprachschulaufenthalt in England entschied er sich, auf der Insel die Matura abzuschliessen und Kriminalistik zu studieren. Danach folgte ein zweijähriger Einsatz als Knecht auf einem nordirischen Bauernhof. Von 2011 bis 2016 studierte er Veterinärmedizin an der Vetsuisse-Fakultät der Universität Bern. Mit seiner Masterarbeit zur Moderhinke erlangte er seinen Abschluss. Darauf arbeitete er vier Jahre im Tierspital Bern. 2021 wurde er auf eine freie Tierarztstelle in Altdorf aufmerksam. «Den Kanton Uri kannte ich noch nicht, aber die Braunviehrasse hatte es mir angetan», schmunzelt er. Wohl war ihm anfänglich das «Ürner Tytsch» fremd, doch er überwand mit frohem Gemüt und der Unterstützung der Bauern die Sprachbarriere. 2024 übernahm er von Dr. Thomas Stadler die Geschäftsleitung der Gross- und Nutztierpraxis Uri AG. Sein Kollege ist seither Ansprechpartner für die Kleintiermedizin.
Inzwischen hat sich die Agenda an diesem Morgen gefüllt. Zuerst noch ein Blick am Labortisch in den Inkubator mit verschiedenen Milchkulturen. «Die Untersuchung von Milchproben auf den Erreger «Staphylococcus aureus» ist entscheidend für die Bekämpfung von Euterentzündungen», hält Butty fest. Der Nachweis des Mastitis-Erregers ist klar ersichtlich. In einer Petrischale sind die Bakterien zu einem Plättchen neben dem Penicillintropfen angewachsen. Es gilt daher, ein anderes Antibiotikum beim erkrankten Tier anzuwenden. Die Übertragung der Erreger erfolgt bei Kühen über den Melkakt.
Impfung als wichtigste Massnahme
Wir starten kurz nach acht Uhr ins Schächental. Zeit, um über die aktuelle Virusinfektion BTV der Wiederkäuer zu sprechen. Seit letztem Herbst ist die Blauzungenkrankheit auch im Urnerland auf dem Vormarsch. Sie wird durch Gnitzen, ein bis drei Millimeter grosse Mücken, bei einem Stich übertragen. Sobald die Aussentemperatur im Frühling zwölf Grad übersteigt, werden sie aktiv. Fieber, Entzündungen mit schaumigem Speichelfluss, Ödeme im Kopfbereich, Lahmheit und Fehlgeburten sind einige der Symptome. «Die Impfung ist die einzige Massnahme, mit der die Wiederkäuer und Kameliden vor einer schweren Krankheit geschützt werden können», sagt Butty mit besorgtem Gesicht. «So können auch langfristig massive wirtschaftliche Schäden verhindert werden.» Für eine Grundimmunisierung seien zwei Injektionen im Abstand von drei bis vier Wochen erforderlich. Über 4500 Tiere wurden im Kanton Uri bereits geimpft. Der Bund beteiligt sich an den Kosten.
Inzwischen sind wir beim Bauernhof Emmetten in Bürglen eingetroffen. Die fünfjährige, trächtige Kuh Halma hat Fieber. Eine Blutentnahme beim Schwanzansatz soll mit dem Glutal-Test Klarheit verschaffen. Verdickt sich das Blut in kurzer Zeit liegt eine Entzündung vor. Tatsächlich, der Befund ist schon nach zwei Minuten klar. Das Abhören des Bauchraums verdeutlicht die Diagnose. «Fremdkörper bedingte Entzündungen des Bauchfells sind bei den Wiederkäuern wohlbekannt», sagt Tierarzt Butty. Metallische Gegenstände bleiben bei der schnellen Futteraufnahme im Netzmagen liegen. Scharfe Kanten und Spitzen können bei der Perforierung auch andere Organe verletzen. Für Abhilfe kann ein Kuhmagenmagnet sorgen. Einmal geschluckt, werden metallische Fremdkörper wie Nägel, Schrauben, Drahtstücke, etc. gebunden. «Der Magnet verbleibt bis zum Lebensende des Tieres im Netzmagen», erklärt er.
Geduldig lässt Kuh Halma die intravenöse Verabreichung von Antibiotika und einem Schmerzmittel über sich ergehen. Mit den Hinterbeinen höherstehend gelingt es auf der nahen Weide, den Magneten zielbestimmt in den Schlund des Tieres einzuführen. Bauer Peter Riedi ist froh. Das Tierwohl liegt ihm sehr am Herzen. Der Bluterguss bei der Kuh Orewa erweist sich zum Glück als harmlos.
Die Enthornung eines Kalbs, das später auswärts in einem Laufstall gehalten wird, steht noch auf dem Programm. Das fünfwöchige Jungtier lässt die Prozedur dank der Betäubung und dem injizierten Schmerzmittel schnell geschehen. Die Verödung der Hornanlagen geschieht mit einem gasbetriebenen Enthornungsgerät. Ein besonderes Augenmerk gilt beim Entfernen auch dem umliegenden Gewebe. Noch die Einträge ins Behandlungsjournal, ein kräftiger Händedruck und Dank zum Abschied und schon geht’s weiter Richtung Spiringen.
Auch der Doktor muss verarztet werden
An Erlebnissen fehlt es Marc Butty nicht. Sei es mit Helikopter, Snowboard oder zu Fuss im knietiefen Schnee abgelegene Höfe zu erreichen oder schwierigen Geburten mit allen Kräften beizustehen. «Das Schönste für mich ist eine erfolgreiche Geburt», sagt er mit einem Strahlen. Gelegentlich muss der ehemalige Kompaniekommandant aber auch hart im Nehmen sein. Letztes Jahr traf ihn ein Kuhhorn am Hals. Es blutete stark und Nähen war später im Tal angesagt. «Desinfektionsmittel und Verbandstoffe habe ich immer griffbereit», sagt er nachdenklich und zeigt am linken Bein einen kürzlichen Bluterguss von einem Kuhtritt.
Steil und kurvenreich ist die Fahrt zum Hof Butzli von Karl Arnold auf 1400 Meter Höhe. Zum Glück ist die Strasse schneefrei. Atemberaubend ist der Blick auf das eingeschneite Wängihorn und den Gross Spitzen auf der anderen Talseite. Das zweijährige Rind Lilian fiebert. Das Abhören der Lunge mit einem Stethoskop ist angesagt. Eine Blutprobe soll mehr Klarheit schaffen. Erleichterung bringt dem Tier ein Entzündungshemmer bis zur definitiven Diagnose. Nur die Halsbandglocken von zwei Ziegen sind im Stall zu hören. Gebannt verfolgen die trächtigen Rinder das Geschehen. Seelenruhig äugt der zweijährige Muni hinüber. Routiniert nimmt Marc Butty Trächtigkeits- und gynäkologische Untersuchungen vor. Mit den Fingern, eingepackt in einem Veterinär-Handschuh mit Schulterschutz, tastet er jeweils den Uterus ab. Mit dem Ultraschallgerät lässt sich die Trächtigkeit genauer untersuchen und auf einem Bildschirm abbilden. Geschick und Feingefühl braucht es dabei wie physische Belastbarkeit, wenn man dem Tier so nahe ist. Ein Kuhfladen folgt dem nächsten und die Kuhhörner sind im Blickwinkel. Fast alle Tiere sind trächtig, was will man mehr?
Es kann hektischer sein
Nach einem kurzen Schwatz geht es weiter zu einem Schafbauern. Die Moderhinke belastet seine Tiere seit längerer Zeit. Die schmerzhafte Klauenkrankheit lässt sich hier nur mit einer Sanierung des Betriebes ausmerzen. Nun scheint es so weit zu sein. Doch nicht alle Bedenken sind aus dem Weg geräumt. Weitere viertelstündige desinfizierende Klauenbäder sind nötig. Dafür ist die Ultraschalluntersuchung der Auen erfreulich. An Nachwuchs wird es nicht fehlen.
Die Uhr rückt vor. Kurz vor 12 Uhr gilt es noch einen Augenschein mit Blutproben in einem Viehstall zu nehmen. Milchproben haben eine erhöhte Antikörperzahl angezeigt. «Wo könnten die Tiere Kontakt mit Viren gehabt haben?», ist die Frage. Der Laborbericht wird dann die Behandlung vorgeben.
Ein ereignisreicher Morgen ist vorbei. «Er kann aber viel hektischer sein», sagt Marc Butty beim Abschied. Tierarzt zu sein, ist für ihn Passion und Berufung zugleich. «Für eure Tiere versuchen wir Berge zu versetzen», sagt er mit welschem Charme. Aber wo holt er sich dazu die nötige Energie? Seine sechs Schwarznasenschafe sind in der Freizeit sein Ein und Alles.

Kommentare
Bitte beachten Sie unsere Richtlinien, die Kommentare werden von uns moderiert.
Zu diesem Thema wurden noch keine Kommentare geschrieben.